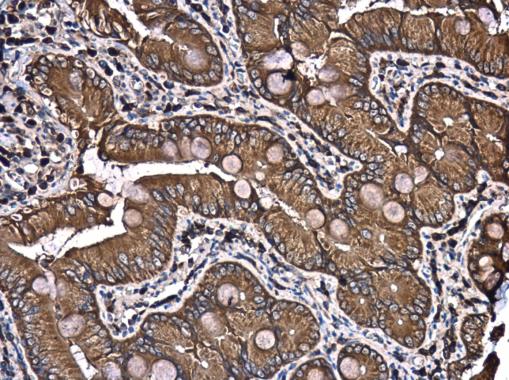
PATJ antibody [N1N2], N-term

相关产品推荐更多 >
万千商家帮你免费找货
0 人在求购买到急需产品
- 详细信息
- 文献和实验
- 技术资料
- 免疫原:
Recombinant protein encompassing a sequence within the N-terminus region of human PATJ. The exact sequence is proprietary.
- 亚型:
IgG
- 形态:
Liquid
- 保存条件:
Store as concentrated solution. Centrifuge briefly prior to opening vial. For short-term storage (1-2 weeks), store at 4ºC. For long-term storage, aliquot and store at -20ºC or below. Avoid multiple freeze-thaw cycles.
- 克隆性:
Polyclonal
- 标记物:
Unconjugated
- 适应物种:
Human, Rat
- 保质期:
12 months from the shipping date of the product.
- 抗原来源:
Human
- 目录编号:
GTX117767
- 级别:
Primary Antibodies
- 库存:
Available
- 供应商:
GeneTex
- 宿主:
Rabbit
- 应用范围:
WB, IHC-P
- 浓度:
1 mg/ml (Please refer to the vial label for the specific concentration.)
- 靶点:
PATJ
- 抗体英文名:
PATJ antibody [N1N2], N-term
- 抗体名:
PATJ 抗体 [N1N2], N-term
- 规格:
100 μl/25 μl
| 规格: | 100 μl | 产品价格: | ¥4000.0 |
|---|---|---|---|
| 规格: | 25 μl | 产品价格: | ¥1700.0 |
Whole cell extract (30 μg) was separated by 5% SDS-PAGE, and the membrane was blotted with PATJ antibody [N1N2], N-term (GTX117767) diluted at 1:500.
PATJ antibody [N1N2], N-term detects PATJ protein at cytoplasm in rat duodenum by immunohistochemical analysis.
Sample: Paraffin-embedded rat duodenum.
PATJ antibody [N1N2], N-term (GTX117767) diluted at 1:500.
Antigen Retrieval: Citrate buffer, pH 6.0, 15 min
风险提示:丁香通仅作为第三方平台,为商家信息发布提供平台空间。用户咨询产品时请注意保护个人信息及财产安全,合理判断,谨慎选购商品,商家和用户对交易行为负责。对于医疗器械类产品,请先查证核实企业经营资质和医疗器械产品注册证情况。
文献和实验In the field of therapeutic recombinant proteins, monoclonal antibodies (mAbs) have achieved a rising success with more than 30 mAbs that have reached the market in the past 20 years. From a structural standpoint, one of the most important
to protect the antibody. These should be stored in smaller aliquots (about 1 ml) and frozen for long term storage though the protected solution is also stable for months at four degrees. Ascites fluid: This is a bit more problematic as it may contain
Materials 0.1M NaHC03 pH9 DMSO NHS-Biotin (N-Hydroxysuccinimidobiotin, Sigma #H-1759) PBS Procedure Dialyze the sample against carbonate buffer. After dialysis, adjust
技术资料暂无技术资料 索取技术资料

![Japanese encephalitis virus Envelope antibody [HL2517]](https://custom.dxycdn.com/trademd/upload/pic/2013/11/12/A1383891150.jpg!small.t.1)

![M13 antibody [E1] (Biotin)](https://img1.dxycdn.com/2022/0328/519/6321971489597300453-14.jpg!wh200)


